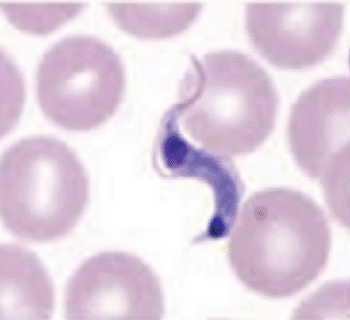
Imagen B: Tripomastigote de T, cruzi en un frotis de sangre (Fotografía cortesía de los Centros para el Control y Prevención de Enfermedades de los EUA).

Ignoran el chagas en comunidades más pobres de América del Norte
By LabMedica International staff writers
Posted on 16 Dec 2013
Una causa importante de enfermedad cardiaca, la causada por el Trypanosoma cruzi se sigue pasando por alto en las comunidades más pobres de América del Norte.Posted on 16 Dec 2013
La enfermedad de Chagas es una infección parasitaria que se transmite más comúnmente a través de insectos triatominos, hematófagos, pero también se puede transmitir a través del embarazo, la transfusión de sangre, y los alimentos o bebidas contaminadas.
Científicos de la Escuela Nacional de Medicina Tropical en la Facultad de Medicina Baylor (Houston TX, EUA) y sus colegas han establecido un vínculo entre la pobreza y la transmisión de la enfermedad de Chagas que se deriva, en gran parte, de las viviendas de baja calidad, que facilita la invasión del triatomino, junto con la falta de acceso a una atención sanitaria adecuada y de atención prenatal.
Cuando no se trata en la fase aguda, la enfermedad se vuelve crónica y hasta el 30% o más de las personas infectadas progresará a la miocardiopatía chagásica o enfermedad megavisceral, asociada con la morbilidad debilitante o la muerte. Hoy en día, la enfermedad de Chagas es la principal causa de enfermedades del corazón entre las personas que viven en la pobreza extrema en el Hemisferio Occidental, sobre todo en América Latina, donde es una importante causa de muerte por parásitos. El diagnóstico de la enfermedad de Chagas se puede hacer mediante la observación del parásito en un frotis de sangre por examen microscópico. Se realiza una preparación de gota gruesa y fina y se tiñen para la visualización de los parásitos. Sin embargo, un frotis de sangre funciona bien sólo en la fase aguda de la infección cuando se pueden ver los parásitos circulando en la sangre.
La enfermedad de Chagas infecta a alrededor de 10 millones de personas en todo el mundo; sin embargo, se sabe mucho menos acerca de la carga real de la enfermedad en América del Norte. Según algunos cálculos, México ocupa el tercer lugar y los Estados Unidos, el séptimo, en términos del número de personas infectadas con la enfermedad de Chagas en el hemisferio occidental, donde se producen el 99% de los casos. También se estima que 40.000 mujeres norteamericanas embarazadas pueden estar infectados con T. cruzi en un momento dado, lo que resulta en 2.000 casos congénitos través de la transmisión de madre a hijo.
La falta de instalaciones para ofrecer diagnósticos y tratamientos de la enfermedad de Chagas ha impedido que las personas en situación de riesgo e infectadas, reciban la atención crítica y que frecuentemente, salva vidas, que necesitan. Si bien en la actualidad existen dos tratamientos farmacológicos, que causan efectos adversos no deseables, no son seguros para las mujeres embarazadas, y no están aprobados para su uso en los EUA Bernard Pecoul, MD, MPH, director ejecutivo de la Iniciativa de Medicamentos para las Enfermedades Olvidadas (DNDi, Ginebra, Suiza) y coautor del estudio, dijo: “Es urgente diagnosticar y tratar a los pacientes con lo que tenemos disponible hoy en día, hasta que los esfuerzos de investigación y desarrollo ofrezcan verdaderos avances para los millones de personas que lo necesitan”. El estudio fue publicado el 31 de octubre de 2013, en la revista Public Library of Science Neglected Tropical Diseases.
Enlaces relacionados:
Baylor College of Medicine
Drugs for Neglected Diseases initiative